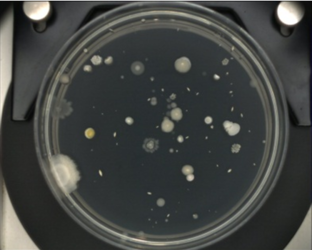
塩素処理の効果（原水）の写真

ここから本文です。
塩素処理の効果
最終更新日 2024年1月22日
水道水は塩素(次亜塩素酸ナトリウム)で消毒することによって、そのまま安心して飲めるよう安全性が保たれています。
塩素は雑菌や病原菌などに対して強力な殺菌力を持っていますが、水道水に含まれる濃度では水道水を一生飲み続けても健康には影響はありません。
残留塩素について
塩素は水道水中に残るため、消毒効果が持続し、雑菌の発生を防ぎます。
一般細菌検査
消毒効果を確認するための検査項目の一つが「一般細菌」で、水道水中の細菌による汚染を把握する指標とされています。
下の写真は、水道水と原水で一般細菌検査を行った結果です。
 塩素消毒あり(水道水)
塩素消毒あり(水道水)
塩素消毒なし(原水)
塩素消毒なし(原水)
浄水処理を実施し、消毒を行った水道水では一般細菌が死滅していますが、浄水処理をしていない原水では、一般細菌のかたまり(集落)である白や黄色の斑点が見られます。
水質基準における「一般細菌」は水道水中の細菌による汚染を把握する指標とされ、1ミリリットルの水道水を特定の培地を用いて36±1℃で24±2時間培養したときに形成される集落数が100以下であることと規定されています。
このページへのお問合せ
ページID:678-586-291







